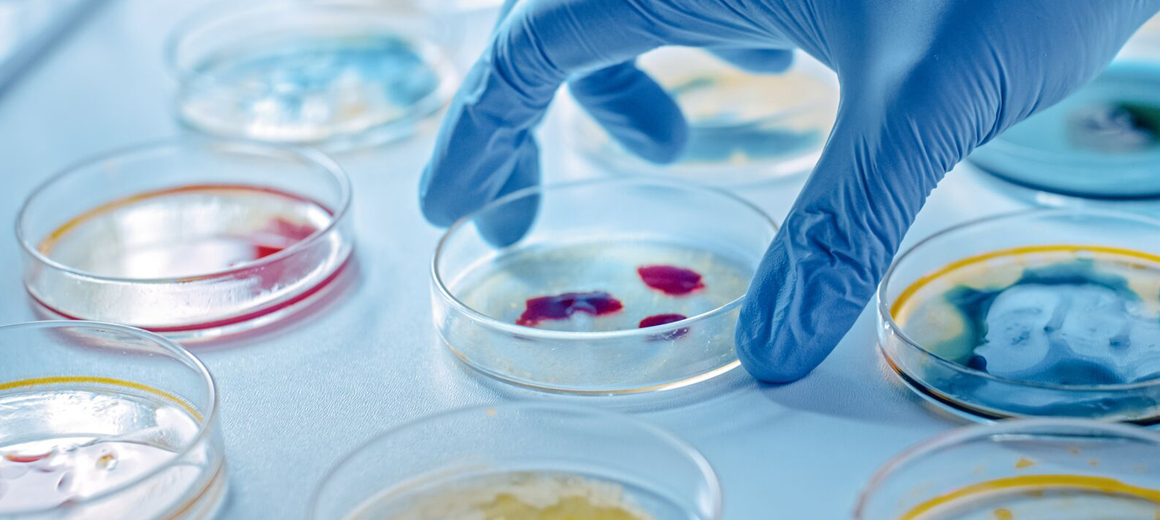

Treinamentos
Com tradição acadêmica e sólida atuação técnica, o LABTERMO oferece treinamentos especializados voltados à qualificação de profissionais das indústrias de alimentos, bebidas, ingredientes, farmacêutica e cosmética. Nossos cursos são ministrados por especialistas com ampla experiência em microbiologia aplicada, processos térmicos, biossegurança e controle de qualidade, com abordagem atualizada e foco em aplicação prática.
As capacitações podem ser realizadas in company, online ou em formato teórico-prático presencial, adaptando-se às necessidades específicas de cada empresa ou equipe. Os conteúdos abrangem desde fundamentos microbiológicos até temas avançados, como microbiologia preditiva, esporos bacterianos, bolores termoresistentes, Hurdle Technology e desafios no controle microbiológico de sucos, águas, extratos e outros produtos sensíveis.
